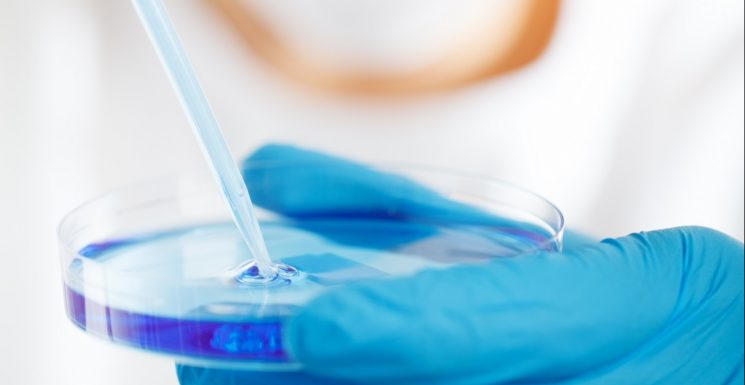

FORMACIÓN ON LINE COVID-19

Dada la situación por el Covid-19, el necesario teletrabajo es una oportunidad para realizar la formación en prevención de riesgos laborales que se desprende de la evaluación de riesgos y la planificación preventiva en las empresas. Nuestra área de Formación […]